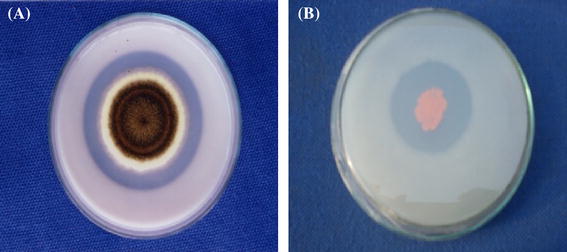
Growth stimulation and management of diseases of ornamental plants

If you are searching about Diversity of culturable P-solubilizing and N2-fixing bacteria in the you've came to the right page. We have 9 Pics about Diversity of culturable P-solubilizing and N2-fixing bacteria in the like 3 Mechanism of growth promotion by phosphate solubilizing bacteria, From Isolation of Phosphate Solubilizing Microbes to Their Formulation and also 3 Mechanism of growth promotion by phosphate solubilizing bacteria. Here you go:
Diversity Of Culturable P-solubilizing And N2-fixing Bacteria In The
 www.researchgate.net
www.researchgate.net culturable solubilizing fixing
Mechanisms Of P Solubilization By Phosphate Solubilizing Bacteria
phosphate solubilizing solubilization mechanisms ahemad
Minerals | Free Full-Text | Use Of Phosphate Solubilizing Bacteria To
 www.mdpi.com
www.mdpi.com minerals monazite ore bearing mdpi text
Growth Stimulation And Management Of Diseases Of Ornamental Plants
link.springer.com
link.springer.com phosphate microorganisms plants growth solubilizing diseases ornamental stimulation perspective fig current management using
From Isolation Of Phosphate Solubilizing Microbes To Their Formulation
 www.semanticscholar.org
www.semanticscholar.org solubilizing microbes phosphate biofertilizers formulation
Phosphate Solubilizing Microbes: Sustainable Ap...
 www.scoop.it
www.scoop.it solubilizing phosphate microbes phosphorus
IJERPH | Free Full-Text | Characteristics Of Inorganic Phosphate
 www.mdpi.com
www.mdpi.com ijerph
PPT - Discovery Of Biofunctional Endophytic Bacteria From Rice
 www.slideserve.com
www.slideserve.com bacteria isolation endophytic rice single colony culture biofunctional discovery sub nba ppt powerpoint presentation pure
3 Mechanism Of Growth Promotion By Phosphate Solubilizing Bacteria
 www.researchgate.net
www.researchgate.net phosphate solubilizing
Growth stimulation and management of diseases of ornamental plants. Solubilizing microbes phosphate biofertilizers formulation. Phosphate solubilizing